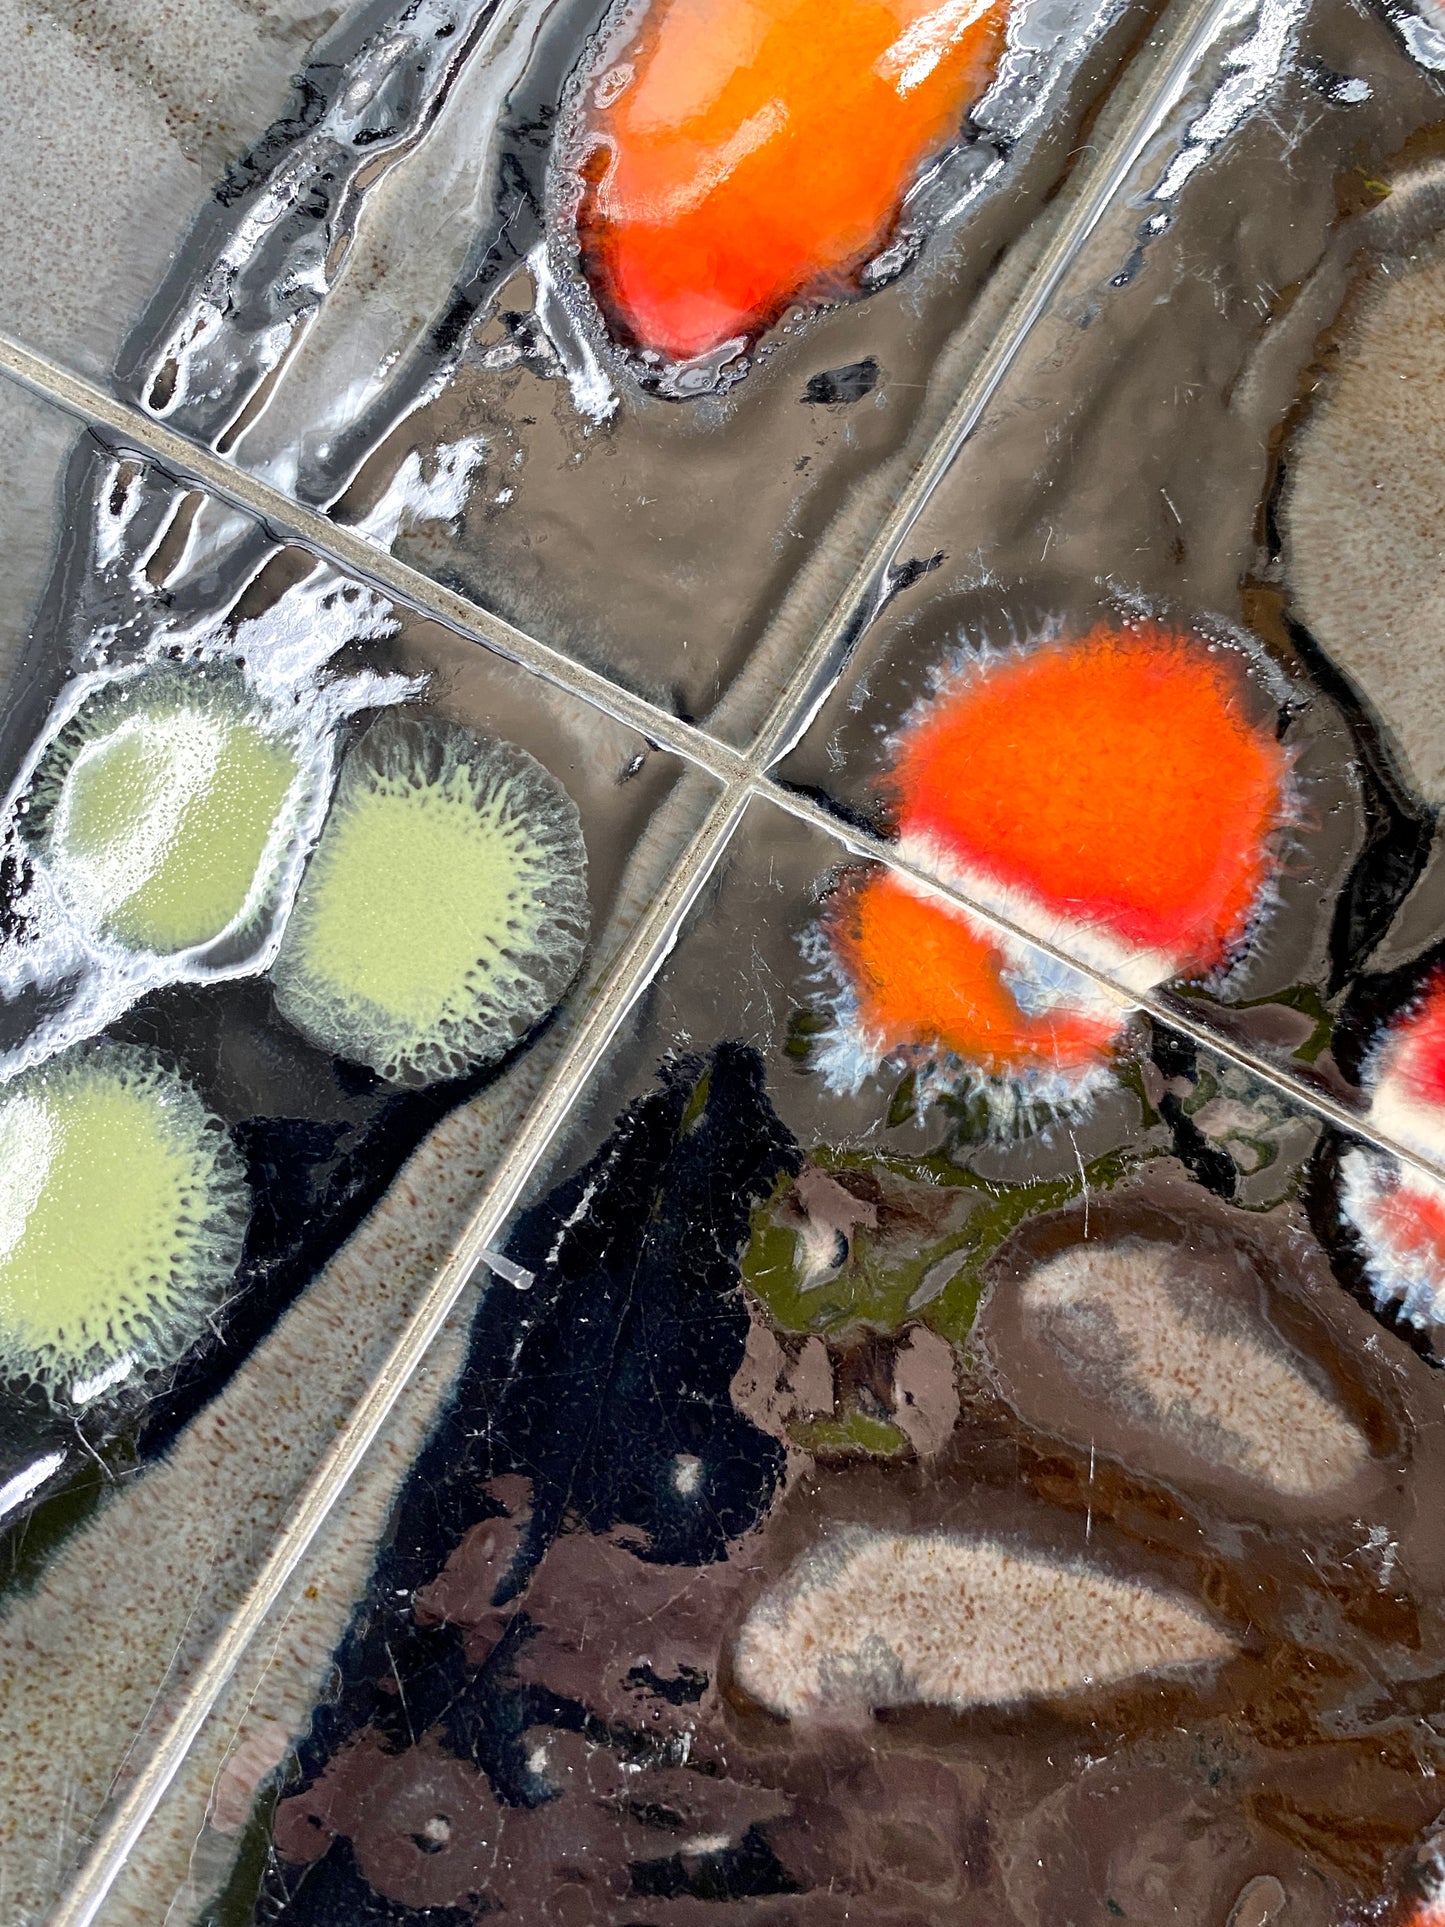

Design54
Extravagante Satztische mit Fat Lava Fliesendekor im Stil von Juliette Belarti, 1970er
Extravagante Satztische mit Fat Lava Fliesendekor im Stil von Juliette Belarti, 1970er
Diese Ware unterliegt der Differenzbesteuerung. Daher wird die im Kaufpreis enthaltene Mehrwertsteuer in der Rechnung nicht gesondert ausgewiesen.
Verfügbarkeit für Abholungen konnte nicht geladen werden
- Kontaktiere uns gerne direkt bei Fragen zur Lieferdauer oder Handhabung
Share
* SATZTISCHE BEISTELLTISCH FLIESENTISCH BELARTI ADRI STIL VINTAGE
zum Verkauf stehen Satztische
* 2er Set Satztische
* Beistelltische / Fliesentische
* extravagantes Fliesendekor im Stil von Juliette Belarti für Adri Belgique
* kein Herstellernachweis
* Abtraktes 70er Jahre Dekor in schwarz, grün, rot-orange auf anthrazitfarbenem Grund
* Chrom-Gestell
* original vintage
Maße größerer Tisch
* Höhe: 38,5 cm
* Breite: 65 cm
* Tiefe: 33 cm
Maße kleiner Tisch
* Höhe: 35,5 cm
* Breite: 55 cm
* Tiefe: 33 cm
Zustand
* sehr guter vintage Zustand
* siehe Fotos

















Jetzt die Designklassiker entdecken
Finde dein einzigartiges Möbelstück bei Design54. Entdecke aufgearbeitete Originale von legendären Designern und Herstellern, die deinem Zuhause den besonderen Touch verleihen. Ob ein klassisches Sofa von Knoll, ein Stuhl von Eames oder ein ikonischer Tisch von Cassina – bei uns findest du Möbel, die nicht nur gut aussehen, sondern auch Geschichte erzählen.
Shoppe jetzt und erlebe zeitloses Design in perfektem Zustand.
Vertrauen & Qualität – Deine Vorteile bei Design54
- Originale Designklassiker von weltbekannten Designern und Herstellern
- Second-hand Möbelstücke, sorgfältig aufgearbeitet und in Top-Zustand
- Schnelle Lieferung innerhalb Deutschlands
- 14 Tage Rückgaberecht für ein sicheres Einkaufserlebnis
- Faire Preise für einzigartige Designmöbel